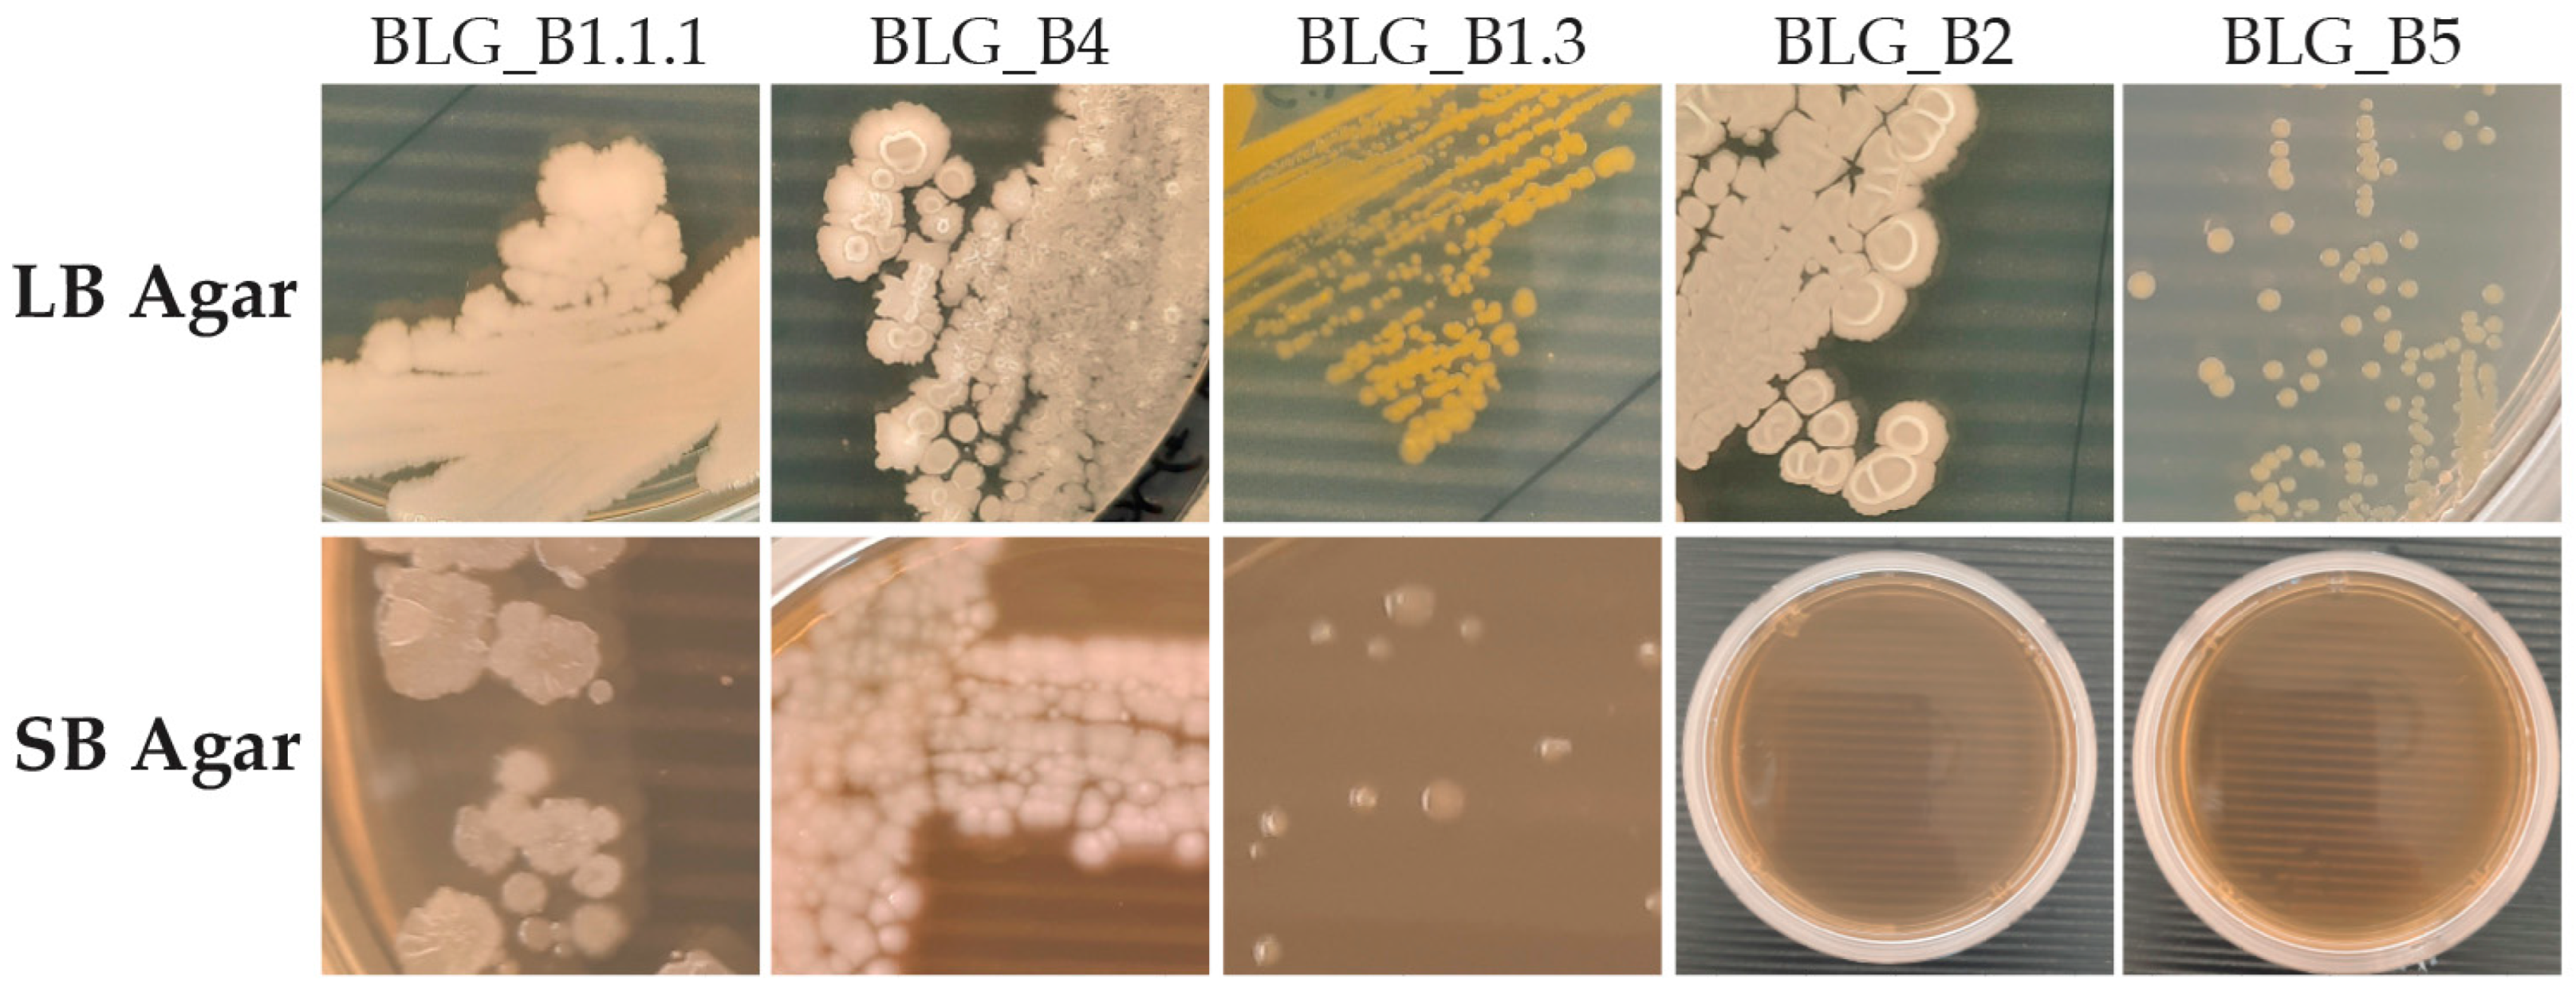
Microbiolres 16 00055 g008

Broad Spectrum Antimicrobial Activity of Bacteria Isolated from Vitis vinifera Leaves
Abstract
1. Introduction
2. Materials and Methods
2.1. Selection of the V. vinifera Varieties
2.2. Bacteria Isolation and Culture Conditions
2.3. Preparation of P. viticola and Other Pathogens
2.4. Screening of Bacterial Isolates Against P. viticola on Leaf Disks
2.5. Morphological and Molecular Identification of Selected Bacteria
2.6. Exspression Analysis of Effector Genes of P. viticola
2.7. Further Characterization Activity of Selected Bacteria
2.8. Statistical Analysis
3. Results
3.1. Selection of Niches Suitable for the Isolation of Microorganisms
3.2. Semi-Selective Isolation of Bacteria and Evaluation of Antagonist Activity Against P. viticola
3.3. Morphological and Molecular Identification of Selected Bacteria
3.4. Expression Analysis of Effector Genes of P. viticola
3.5. Further Characterization Activity of Selected Bacteria
4. Discussion
5. Conclusions
Supplementary Materials
Author Contributions
Funding
Institutional Review Board Statement
Informed Consent Statement
Data Availability Statement
Acknowledgments
Conflicts of Interest
References
- OIV. State of the World Vine and Wine Sector in 2022. 2023. Available online: https://www.oiv.int/sites/default/files/documents/oiv_state_of_the_world_vine_and_wine_sector_in_2022_2.pdf (accessed on 15 January 2025).
- Darriaut, R.; Lailheugue, V.; Masneuf-Pomarède, I.; Marguerit, E.; Martins, G.; Compant, S.; Ballestra, P.; Upton, S.; Ollat, N.; Lauvergeat, V. Grapevine Rootstock and Soil Microbiome Interactions: Keys for a Resilient Viticulture. Hortic. Res. 2022, 9, uhac019. [Google Scholar] [CrossRef]
- Berg, G.; Smalla, K. Plant Species and Soil Type Cooperatively Shape the Structure and Function of Microbial Communities in the Rhizosphere. FEMS Microbiol. Ecol. 2009, 68, 1–13. [Google Scholar] [CrossRef] [PubMed]
- Pinto, C.; Pinho, D.; Sousa, S.; Pinheiro, M.; Egas, C.; Gomes, A.C. Unravelling the Diversity of Grapevine Microbiome. PLoS ONE 2014, 9, e85622. [Google Scholar] [CrossRef] [PubMed]
- Swift, J.F.; Hall, M.E.; Harris, Z.N.; Kwasniewski, M.T.; Miller, A.J. Grapevine Microbiota Reflect Diversity among Compartments and Complex Interactions within and among Root and Shoot Systems. Microorganisms 2021, 9, 92. [Google Scholar] [CrossRef] [PubMed]
- Renouf, V.; Claisse, O.; Lonvaud-Funel, A. Inventory and Monitoring of Wine Microbial Consortia. Appl. Microbiol. Biotechnol. 2007, 75, 149–164. [Google Scholar] [CrossRef]
- Fournier, P.; Pellan, L.; Barroso-Bergadà, D.; Bohan, D.A.; Candresse, T.; Delmotte, F.; Dufour, M.-C.; Lauvergeat, V.; Le Marrec, C.; Marais, A.; et al. The Functional Microbiome of Grapevine throughout Plant Evolutionary History and Lifetime. Advances in Ecological Research; Academic Press: Cambridge, MA, USA, 2022; pp. 27–99. [Google Scholar]
- Cui, S.; Zhou, L.; Fang, Q.; Xiao, H.; Jin, D.; Liu, Y. Growth Period and Variety Together Drive the Succession of Phyllosphere Microbial Communities of Grapevine. Sci. Total Environ. 2024, 950, 175334. [Google Scholar] [CrossRef] [PubMed]
- Wicaksono, W.A.; Morauf, C.; Müller, H.; Abdelfattah, A.; Donat, C.; Berg, G. The Mature Phyllosphere Microbiome of Grapevine Is Associated with Resistance against Plasmopara Viticola. Front. Microbiol. 2023, 14, 1149307. [Google Scholar] [CrossRef] [PubMed]
- Perazzolli, M.; Antonielli, L.; Storari, M.; Puopolo, G.; Pancher, M.; Giovannini, O.; Pindo, M.; Pertot, I. Resilience of the Natural Phyllosphere Microbiota of the Grapevine to Chemical and Biological Pesticides. Appl. Environ. Microbiol. 2014, 80, 3585–3596. [Google Scholar] [CrossRef]
- Deyett, E.; Rolshausen, P.E. Endophytic Microbial Assemblage in Grapevine. FEMS Microbiol. Ecol. 2020, 96, fiaa053. [Google Scholar] [CrossRef]
- Bruisson, S.; Zufferey, M.; L’Haridon, F.; Trutmann, E.; Anand, A.; Dutartre, A.; De Vrieze, M.; Weisskopf, L. Endophytes and Epiphytes From the Grapevine Leaf Microbiome as Potential Biocontrol Agents Against Phytopathogens. Front. Microbiol. 2019, 10, 2726. [Google Scholar] [CrossRef]
- Dagostin, S.; Schärer, H.-J.; Pertot, I.; Tamm, L. Are There Alternatives to Copper for Controlling Grapevine Downy Mildew in Organic Viticulture? Crop Prot. 2011, 30, 776–788. [Google Scholar] [CrossRef]
- Zhang, X.; Zhou, Y.; Li, Y.; Fu, X.; Wang, Q. Screening and Characterization of Endophytic Bacillus for Biocontrol of Grapevine Downy Mildew. Crop Prot. 2017, 96, 173–179. [Google Scholar] [CrossRef]
- Tiwari, P.; Kang, S.; Bae, H. Plant-Endophyte Associations: Rich yet under-Explored Sources of Novel Bioactive Molecules and Applications. Microbiol. Res. 2023, 266, 127241. [Google Scholar] [CrossRef] [PubMed]
- de Paula Nogueira Cruz, F.; Cristina Bogas, A.; Paiva de Sousa, C. Plant-Associated Microorganisms as a Potent Bio-Factory of Active Molecules against Multiresistant Pathogens. In Antimicrobial Resistance—A One Health Perspective; IntechOpen: London, UK, 2021. [Google Scholar] [CrossRef]
- Köhl, J.; Kolnaar, R.; Ravensberg, W.J. Mode of Action of Microbial Biological Control Agents Against Plant Diseases: Relevance Beyond Efficacy. Front. Plant Sci. 2019, 10, 845. [Google Scholar] [CrossRef]
- Raaijmakers, J.M.; Mazzola, M. Diversity and Natural Functions of Antibiotics Produced by Beneficial and Plant Pathogenic Bacteria. Annu. Rev. Phytopathol. 2012, 50, 403–424. [Google Scholar] [CrossRef] [PubMed]
- Bois, B.; Zito, S.; Calonnec, A. Climate vs Grapevine Pests and Diseases Worldwide: The First Results of a Global Survey. OENO One 2017, 51, 133–139. [Google Scholar] [CrossRef]
- Cooper, J.; Dobson, H. The Benefits of Pesticides to Mankind and the Environment. Crop Prot. 2007, 26, 1337–1348. [Google Scholar] [CrossRef]
- Mwaka, O.; Mwamahonje, A.; Nene, W.; Rweyemamu, E.; Maseta, Z. Pesticides Use and Its Effects on Grape Production: A Review. Sustain. Environ. 2024, 10, 2366555. [Google Scholar] [CrossRef]
- FAO. Pesticides Use and Trade. 1990–2022. 2024. Available online: https://www.fao.org/statistics/highlights-archive/highlights-detail/pesticides-use-and-trade-1990-2022/en (accessed on 15 January 2022).
- Massi, F.; Torriani, S.F.F.; Borghi, L.; Toffolatti, S.L. Fungicide Resistance Evolution and Detection in Plant Pathogens: Plasmopara Viticola as a Case Study. Microorganisms 2021, 9, 119. [Google Scholar] [CrossRef] [PubMed]
- Mboup, M.K.; Sweigard, J.W.; Carroll, A.; Jaworska, G.; Genet, J. Genetic Mechanism, Baseline Sensitivity and Risk of Resistance to Oxathiapiprolin in Oomycetes. Pest. Manag. Sci. 2022, 78, 905–913. [Google Scholar] [CrossRef]
- Cherrad, S.; Gillet, B.; Dellinger, J.; Bellaton, L.; Roux, P.; Hernandez, C.; Steva, H.; Perrier, L.; Vacher, S.; Hughes, S. New Insights from Short and Long Reads Sequencing to Explore Cytochrome b Variants in Plasmopara Viticola Populations Collected from Vineyards and Related to Resistance to Complex III Inhibitors. PLoS ONE 2023, 18, e0268385. [Google Scholar] [CrossRef] [PubMed]
- Aktar, W.; Sengupta, D.; Chowdhury, A. Impact of Pesticides Use in Agriculture: Their Benefits and Hazards. Interdiscip. Toxicol. 2009, 2, 1–12. [Google Scholar] [CrossRef] [PubMed]
- Fouillet, E.; Delière, L.; Chartier, N.; Munier-Jolain, N.; Cortel, S.; Rapidel, B.; Merot, A. Reducing Pesticide Use in Vineyards. Evidence from the Analysis of the French DEPHY Network. Eur. J. Agron. 2022, 136, 126503. [Google Scholar] [CrossRef]
- Hahn, M. The Rising Threat of Fungicide Resistance in Plant Pathogenic Fungi: Botrytis as a Case Study. J. Chem. Biol. 2014, 7, 133–141. [Google Scholar] [CrossRef] [PubMed]
- Climent, M.J.; Herrero-Hernández, E.; Sánchez-Martín, M.J.; Rodríguez-Cruz, M.S.; Pedreros, P.; Urrutia, R. Residues of Pesticides and Some Metabolites in Dissolved and Particulate Phase in Surface Stream Water of Cachapoal River Basin, Central Chile. Environ. Pollut. 2019, 251, 90–101. [Google Scholar] [CrossRef]
- Teysseire, R.; Manangama, G.; Baldi, I.; Carles, C.; Brochard, P.; Bedos, C.; Delva, F. Determinants of Non-Dietary Exposure to Agricultural Pesticides in Populations Living Close to Fields: A Systematic Review. Sci. Total Environ. 2021, 761, 143294. [Google Scholar] [CrossRef] [PubMed]
- Damalas, C.A.; Eleftherohorinos, I.G. Pesticide Exposure, Safety Issues, and Risk Assessment Indicators. Int. J. Environ. Res. Public. Health 2011, 8, 1402–1419. [Google Scholar] [CrossRef]
- Verma, A.; Shameem, N.; Jatav, H.S.; Sathyanarayana, E.; Parray, J.A.; Poczai, P.; Sayyed, R.Z. Fungal Endophytes to Combat Biotic and Abiotic Stresses for Climate-Smart and Sustainable Agriculture. Front. Plant Sci. 2022, 13, 953836. [Google Scholar] [CrossRef]
- Furuya, S.; Mochizuki, M.; Aoki, Y.; Kobayashi, H.; Takayanagi, T.; Shimizu, M.; Suzuki, S. Isolation and Characterization of Bacillus Subtilis KS1 for the Biocontrol of Grapevine Fungal Diseases. Biocontrol Sci. Technol. 2011, 21, 705–720. [Google Scholar] [CrossRef]
- Hamaoka, K.; Aoki, Y.; Suzuki, S. Isolation and Characterization of Endophyte Bacillus Velezensis KOF112 from Grapevine Shoot Xylem as Biological Control Agent for Fungal Diseases. Plants 2021, 10, 1815. [Google Scholar] [CrossRef] [PubMed]
- Deng, Y.; Chen, Z.; Ruan, C.; Xiao, R.; Lian, H.; Liu, B.; Chen, M.; Wang, J. Antifungal Activities of Bacillus Velezensis FJAT-52631 and Its Lipopeptides against Anthracnose Pathogen Colletotrichum Acutatum. J. Basic. Microbiol. 2023, 63, 594–603. [Google Scholar] [CrossRef]
- Fira, D.; Dimkić, I.; Berić, T.; Lozo, J.; Stanković, S. Biological Control of Plant Pathogens by Bacillus Species. J. Biotechnol. 2018, 285, 44–55. [Google Scholar] [CrossRef] [PubMed]
- Baukova, A.; Bogun, A.; Sushkova, S.; Minkina, T.; Mandzhieva, S.; Alliluev, I.; Jatav, H.S.; Kalinitchenko, V.; Rajput, V.D.; Delegan, Y. New Insights into Pseudomonas Spp.-Produced Antibiotics: Genetic Regulation of Biosynthesis and Implementation in Biotechnology. Antibiotics 2024, 13, 597. [Google Scholar] [CrossRef] [PubMed]
- Castro Tapia, M.P.; Madariaga Burrows, R.P.; Ruiz Sepúlveda, B.; Vargas Concha, M.; Vera Palma, C.; Moya-Elizondo, E.A. Antagonistic Activity of Chilean Strains of Pseudomonas Protegens Against Fungi Causing Crown and Root Rot of Wheat (Triticum aestivum L.). Front. Plant Sci. 2020, 11, 951. [Google Scholar] [CrossRef] [PubMed]
- Furuya, N.; Yamasaky, S.; Nishioka, M.; Shiraishi, I.; Iiyama, K.; Matsuyama, N. Antimicrobial Activities of Pseudomonads against Plant Pathogenic Organisms and Efficacy of Pseudomonas Aeruginosa ATCC7700 against Bacterial Wilt of Tomato. Jpn. J. Phytopathol. 1997, 63, 417–424. [Google Scholar] [CrossRef]
- Duchateau, S.; Crouzet, J.; Dorey, S.; Aziz, A. The Plant-Associated Pantoea Spp. as Biocontrol Agents: Mechanisms and Diversity of Bacteria-Produced Metabolites as a Prospective Tool for Plant Protection. Biol. Control 2024, 188, 105441. [Google Scholar] [CrossRef]
- Walterson, A.M.; Stavrinides, J. Pantoea: Insights into a Highly Versatile and Diverse Genus within the Enterobacteriaceae. FEMS Microbiol. Rev. 2015, 39, 968–984. [Google Scholar] [CrossRef]
- McKinney, H.H. Influence of Soil Temperature and Moisture on Infection of Wheat Seedlings by Helminthosporium sativum. J. Agric. Res. 1923, 26, 195–217. [Google Scholar]
- Bove, F.; Bavaresco, L.; Caffi, T.; Rossi, V. Assessment of Resistance Components for Improved Phenotyping of Grapevine Varieties Resistant to Downy Mildew. Front. Plant Sci. 2019, 10, 1559. [Google Scholar] [CrossRef]
- Kortekamp, A.; Welter, L.; Vogt, S.; Knoll, A.; Schwander, F.; Töpfer, R.; Zyprian, E. Identification, Isolation and Characterization of a CC-NBS-LRR Candidate Disease Resistance Gene Family in Grapevine. Mol. Breed. 2008, 22, 421–432. [Google Scholar] [CrossRef]
- Salerno, A.; D’Amico, M.; Bergamini, C.; Maggiolini, F.A.M.; Vendemia, M.; Prencipe, A.; Catacchio, C.R.; Ventura, M.; Cardone, M.F.; Marsico, A.D. On the Way to the Technological Development of Newly Selected Non-Saccharomyces Yeasts Selected as Innovative Biocontrol Agents in Table Grapes. Microorganisms 2024, 12, 340. [Google Scholar] [CrossRef] [PubMed]
- Abbott, W.S. A Method of Computing the Effectiveness of an Insecticide. J. Econ. Entomol. 1925, 18, 265–267. [Google Scholar] [CrossRef]
- Meier-Kolthoff, J.P.; Göker, M. TYGS is an automated high-throughput platform for state-of-the-art genome-based taxonomy. Nat. Commun. 2019, 10, 2182. [Google Scholar] [CrossRef]
- Xiang, J.; Li, X.; Wu, J.; Yin, L.; Zhang, Y.; Lu, J. Studying the Mechanism of Plasmopara Viticola RxLR Effectors on Suppressing Plant Immunity. Front. Microbiol. 2016, 7, 709. [Google Scholar] [CrossRef]
- Cruz-Silva, A.; Figueiredo, A.; Sebastiana, M. First Insights into the Effect of Mycorrhizae on the Expression of Pathogen Effectors during the Infection of Grapevine with Plasmopara Viticola. Sustainability 2021, 13, 1226. [Google Scholar] [CrossRef]
- Livak, K.J.; Schmittgen, T.D. Analysis of Relative Gene Expression Data Using Real-Time Quantitative PCR and the 2−ΔΔCT Method. Methods 2001, 25, 402–408. [Google Scholar] [CrossRef] [PubMed]
- Luo, G.; Samaranayake, L.P.; Yau, J.Y.Y. Candida Species Exhibit Differential In Vitro Hemolytic Activities. J. Clin. Microbiol. 2001, 39, 2971–2974. [Google Scholar] [CrossRef]
- Katz, D.S. The Streak Plate Protocol; American Society for Microbiology: Washington, DC, USA, 2008; pp. 1–14. [Google Scholar]
- Buxton, R. Blood Agar Plates and Hemolysis Protocols; American Society for Microbiology: Washington, DC, USA, 2005; pp. 1–9. [Google Scholar]
- Lawson, R.G.; Jurs, P.C. New Index for Clustering Tendency and Its Application to Chemical Problems. J. Chem. Inf. Comput. Sci. 1990, 30, 36–41. [Google Scholar] [CrossRef]
- Amarouchi, Z.; Esmaeel, Q.; Sanchez, L.; Jacquard, C.; Hafidi, M.; Vaillant-Gaveau, N.; Ait Barka, E. Beneficial Microorganisms to Control the Gray Mold of Grapevine: From Screening to Mechanisms. Microorganisms 2021, 9, 1386. [Google Scholar] [CrossRef] [PubMed]
- Bettenfeld, P.; Cadena i Canals, J.; Jacquens, L.; Fernandez, O.; Fontaine, F.; van Schaik, E.; Courty, P.-E.; Trouvelot, S. The Microbiota of the Grapevine Holobiont: A Key Component of Plant Health. J. Adv. Res. 2022, 40, 1–15. [Google Scholar] [CrossRef]
- Droby, S.; Wisniewski, M.; Macarisin, D.; Wilson, C. Twenty Years of Postharvest Biocontrol Research: Is It Time for a New Paradigm? Postharvest Biol. Technol. 2009, 52, 137–145. [Google Scholar] [CrossRef]
- Janisiewicz, W.J.; Korsten, L. Biological Control of Postharvest Disease of Fruits. Annu. Rev. Phytopathol. 2002, 40, 411–441. [Google Scholar] [CrossRef]
- Koledenkova, K.; Esmaeel, Q.; Jacquard, C.; Nowak, J.; Clément, C.; Ait Barka, E. Plasmopara Viticola the Causal Agent of Downy Mildew of Grapevine: From Its Taxonomy to Disease Management. Front. Microbiol. 2022, 13, 889472. [Google Scholar] [CrossRef] [PubMed]
- Marsico, A.D.; Velenosi, M.; Perniola, R.; Bergamini, C.; Sinonin, S.; David-Vaizant, V.; Maggiolini, F.A.M.; Hervè, A.; Cardone, M.F.; Ventura, M. Native Vineyard Non-Saccharomyces Yeasts Used for Biological Control of Botrytis Cinerea in Stored Table Grape. Microorganisms 2021, 9, 457. [Google Scholar] [CrossRef]
- Faretra, F.; Di Tonno, A.P. Osservazioni Sulla Sensibilità Di Cultivar Di Vite Alla Peronospora Nell’ambiente Dell’Italia Meridionale. Phytopathol. Mediterr. 1991, 30, 173–176. [Google Scholar]
- Boso, S.; Alonso-Villaverde, V.; Gago, P.; Santiago, J.L.; Martínez, M.C. Susceptibility to Downy Mildew (Plasmopara viticola) of Different Vitis Varieties. Crop Prot. 2014, 63, 26–35. [Google Scholar] [CrossRef]
- Spadaro, D.; Droby, S. Development of Biocontrol Products for Postharvest Diseases of Fruit: The Importance of Elucidating the Mechanisms of Action of Yeast Antagonists. Trends Food Sci. Technol. 2016, 47, 39–49. [Google Scholar] [CrossRef]
- Berg, G. Plant–Microbe Interactions Promoting Plant Growth and Health: Perspectives for Controlled Use of Microorganisms in Agriculture. Appl. Microbiol. Biotechnol. 2009, 84, 11–18. [Google Scholar] [CrossRef] [PubMed]
- Lugtenberg, B.; Kamilova, F. Plant-Growth-Promoting Rhizobacteria. Annu. Rev. Microbiol. 2009, 63, 541–556. [Google Scholar] [CrossRef]
- Trotel-Aziz, P.; Abou-Mansour, E.; Courteaux, B.; Rabenoelina, F.; Clément, C.; Fontaine, F.; Aziz, A. Bacillus Subtilis PTA-271 Counteracts Botryosphaeria Dieback in Grapevine, Triggering Immune Responses and Detoxification of Fungal Phytotoxins. Front. Plant Sci. 2019, 10, 25. [Google Scholar] [CrossRef] [PubMed]
- Trotel-Aziz, P.; Couderchet, M.; Biagianti, S.; Aziz, A. Characterization of New Bacterial Biocontrol Agents Acinetobacter, Bacillus, Pantoea and Pseudomonas Spp. Mediating Grapevine Resistance against Botrytis Cinerea. Environ. Exp. Bot. 2008, 64, 21–32. [Google Scholar] [CrossRef]
- Bustamante, M.I.; Elfar, K.; Eskalen, A. Evaluation of the Antifungal Activity of Endophytic and Rhizospheric Bacteria against Grapevine Trunk Pathogens. Microorganisms 2022, 10, 2035. [Google Scholar] [CrossRef] [PubMed]
- Zhang, J.; Huang, X.; Hou, Y.; Xia, X.; Zhu, Z.; Huang, A.; Feng, S.; Li, P.; Shi, L.; Dong, P. Isolation and Screening of Antagonistic Endophytes against Phytophthora infestans and Preliminary Exploration on Anti-Oomycete Mechanism of Bacillus velezensis 6-5. Plants 2023, 12, 909. [Google Scholar] [CrossRef] [PubMed]
- Hong, S.; Kim, T.Y.; Won, S.-J.; Moon, J.-H.; Ajuna, H.B.; Kim, K.Y.; Ahn, Y.S. Control of Fungal Diseases and Fruit Yield Improvement of Strawberry Using Bacillus Velezensis CE 100. Microorganisms 2022, 10, 365. [Google Scholar] [CrossRef]
- Hein, I.; Gilroy, E.M.; Armstrong, M.R.; Birch, P.R.J. The Zig-zag-zig in Oomycete–Plant Interactions. Mol. Plant Pathol. 2009, 10, 547–562. [Google Scholar] [CrossRef] [PubMed]
- Nürnberger, T.; Brunner, F.; Kemmerling, B.; Piater, L. Innate Immunity in Plants and Animals: Striking Similarities and Obvious Differences. Immunol. Rev. 2004, 198, 249–266. [Google Scholar] [CrossRef] [PubMed]
- Jones, J.D.G.; Dangl, J.L. The Plant Immune System. Nature 2006, 444, 323–329. [Google Scholar] [CrossRef] [PubMed]
- Schornack, S.; Huitema, E.; Cano, L.M.; Bozkurt, T.O.; Oliva, R.; Van Damme, M.; Schwizer, S.; Raffaele, S.; Chaparro-Garcia, A.; Farrer, R.; et al. Ten Things to Know about Oomycete Effectors. Mol. Plant Pathol. 2009, 10, 795–803. [Google Scholar] [CrossRef] [PubMed]
- Ramos, M.; Daranas, N.; Llugany, M.; Tolrà, R.; Montesinos, E.; Badosa, E. Grapevine Response to a Dittrichia Viscosa Extract and a Bacillus Velezensis Strain. Front. Plant Sci. 2022, 13, 1075231. [Google Scholar] [CrossRef] [PubMed]
- Xu, Y.; Wang, L.; Liang, W.; Liu, M. Biocontrol Potential of Endophytic Bacillus Velezensis Strain QSE-21 against Postharvest Grey Mould of Fruit. Biol. Control 2021, 161, 104711. [Google Scholar] [CrossRef]
- Köhl, J.; Postma, J.; Nicot, P.; Ruocco, M.; Blum, B. Stepwise Screening of Microorganisms for Commercial Use in Biological Control of Plant-Pathogenic Fungi and Bacteria. Biol. Control 2011, 57, 1–12. [Google Scholar] [CrossRef]
- Farag, M.R.; Alagawany, M. Erythrocytes as a Biological Model for Screening of Xenobiotics Toxicity. Chem. Biol. Interact. 2018, 279, 73–83. [Google Scholar] [CrossRef] [PubMed]
- Wang, H.; Guo, J.; Chen, X.; He, H. The Metabolomics Changes in Luria–Bertani Broth Medium under Different Sterilization Methods and Their Effects on Bacillus Growth. Metabolites 2023, 13, 958. [Google Scholar] [CrossRef]
- Williams, G.R. Haemolytic Material from Aerobic Sporing Bacilli. J. Gen. Microbiol. 1957, 16, 16–21. [Google Scholar] [CrossRef] [PubMed]
- Bernheimer, A.W.; Grushoff, P. Extracellular Hemolysins of Aerobic Sporogenic Bacilli. J. Bacteriol. 1967, 93, 1541–1543. [Google Scholar] [CrossRef] [PubMed]
- Pan, X.; Chen, X.; Su, X.; Feng, Y.; Tao, Y.; Dong, Z. Involvement of SpoVG in Hemolysis Caused by Bacillus Subtilis. Biochem. Biophys. Res. Commun. 2014, 443, 899–904. [Google Scholar] [CrossRef] [PubMed]
- Sidahmed, O. Possibilities of Biological Control of Bactroceradorsalis (Hendel) (Diptera: Tephritidae) using Bacillus Subtilis/Amyloliquefaciens and Bacillus Sphaericus in Sudan. J. Agric. Food Dev. 2018, 3, 27–33. [Google Scholar] [CrossRef]
- Huang, T.; Geng, H.; Miyyapuram, V.R.; Sit, C.S.; Vederas, J.C.; Nakano, M.M. Isolation of a Variant of Subtilosin A with Hemolytic Activity. J. Bacteriol. 2009, 191, 5690–5696. [Google Scholar] [CrossRef] [PubMed]
- Manyatsi, T.S.; Lin, Y.-H.; Jou, Y.-T. The Isolation and Identification of Bacillus Velezensis ZN-S10 from Vanilla (V. Planifolia), and the Microbial Distribution after the Curing Process. Sci. Rep. 2024, 14, 16339. [Google Scholar] [CrossRef] [PubMed]
- Brutscher, L.M.; Gebrechristos, S.; Garvey, S.M.; Spears, J.L. Genetic and Phenotypic Characterization of Bacillus Velezensis Strain BV379 for Human Probiotic Applications. Microorganisms 2024, 12, 436. [Google Scholar] [CrossRef] [PubMed]
- Doekes, G.; Larsen, P.; Sigsgaard, T.; Baelum, J. IgE Sensitization to Bacterial and Fungal Biopesticides in a Cohort of Danish Greenhouse Workers: The BIOGART Study. Am. J. Ind. Med. 2004, 46, 404–407. [Google Scholar] [CrossRef]
- Castagnola, E.; Fioredda, F.; Barretta, M.A.; Pescetto, L.; Garaventa, A.; Lanino, E.; Micalizzi, C.; Giacchino, R.; Dini, G. Bacillus Sphaericus Bacteraemia in Children with Cancer: Case Reports and Literature Review. J. Hosp. Infect. 2001, 48, 142–145. [Google Scholar] [CrossRef] [PubMed]
- Rogers, G.B.; Hart, C.A.; Mason, J.R.; Hughes, M.; Walshaw, M.J.; Bruce, K.D. Bacterial Diversity in Cases of Lung Infection in Cystic Fibrosis Patients: 16S Ribosomal DNA (RDNA) Length Heterogeneity PCR and 16S RDNA Terminal Restriction Fragment Length Polymorphism Profiling. J. Clin. Microbiol. 2003, 41, 3548–3558. [Google Scholar] [CrossRef] [PubMed]
- Kratz, A. Pantoea Agglomerans as a Cause of Septic Arthritis after Palm Tree Thorn Injury; Case Report and Literature Review. Arch. Dis. Child. 2003, 88, 542–544. [Google Scholar] [CrossRef] [PubMed]

Disclaimer/Publisher’s Note: The statements, opinions and data contained in all publications are solely those of the individual author(s) and contributor(s) and not of MDPI and/or the editor(s). MDPI and/or the editor(s) disclaim responsibility for any injury to people or property resulting from any ideas, methods, instructions or products referred to in the content. |
© 2025 by the authors. Licensee MDPI, Basel, Switzerland. This article is an open access article distributed under the terms and conditions of the Creative Commons Attribution (CC BY) license (https://creativecommons.org/licenses/by/4.0/).
Share and Cite
Mandorino, C.; Maggiolini, F.A.M.; D’Amico, M.; Prencipe, A.; Salerno, A.; Bergamini, C.; Pazzani, C.; Cardone, M.F.; Marsico, A.D. Broad Spectrum Antimicrobial Activity of Bacteria Isolated from Vitis vinifera Leaves. Microbiol. Res. 2025, 16, 55. https://doi.org/10.3390/microbiolres16030055
Mandorino C, Maggiolini FAM, D’Amico M, Prencipe A, Salerno A, Bergamini C, Pazzani C, Cardone MF, Marsico AD. Broad Spectrum Antimicrobial Activity of Bacteria Isolated from Vitis vinifera Leaves. Microbiology Research. 2025; 16(3):55. https://doi.org/10.3390/microbiolres16030055
Chicago/Turabian StyleMandorino, Camilla, Flavia Angela Maria Maggiolini, Margherita D’Amico, Annalisa Prencipe, Antonella Salerno, Carlo Bergamini, Carlo Pazzani, Maria Francesca Cardone, and Antonio Domenico Marsico. 2025. "Broad Spectrum Antimicrobial Activity of Bacteria Isolated from Vitis vinifera Leaves" Microbiology Research 16, no. 3: 55. https://doi.org/10.3390/microbiolres16030055
APA StyleMandorino, C., Maggiolini, F. A. M., D’Amico, M., Prencipe, A., Salerno, A., Bergamini, C., Pazzani, C., Cardone, M. F., & Marsico, A. D. (2025). Broad Spectrum Antimicrobial Activity of Bacteria Isolated from Vitis vinifera Leaves. Microbiology Research, 16(3), 55. https://doi.org/10.3390/microbiolres16030055






